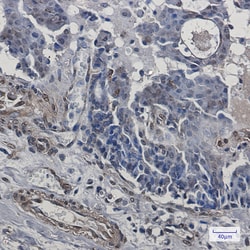
Invitrogen TRIP10 Recombinant Rabbit Monoclonal Antibody (K01_1P58) 100 &mu;L | Buy Online | Invitrogen&trade; | Fisher Scientific

missing translation for 'onlineSavingsMsg'
Learn More
Learn More
Invitrogen™ TRIP10 Recombinant Rabbit Monoclonal Antibody (K01_1P58)
Description
TRIP10 Recombinant Monoclonal Antibody for IHC (P), Western Blot
Required for translocation of GLUT4 to the plasma membrane in response to insulin signaling. Required to coordinate membrane tubulation with reorganization of the actin cytoskeleton during endocytosis. Binds to lipids such as phosphatidylinositol 4,5-bisphosphate and phosphatidylserine and promotes membrane invagination and the formation of tubules. Also promotes CDC42-induced actin polymerization by recruiting WASL/N-WASP which in turn activates the Arp2/3 complex. Actin polymerization may promote the fission of membrane tubules to form endocytic vesicles. Required for the formation of podosomes, actin-rich adhesion structures specific to monocyte-derived cells. May be required for the lysosomal retention of FASLG/FASL.

Specifications
Specifications
| Antigen | TRIP10 |
| Applications | Immunohistochemistry (Paraffin), Western Blot |
| Classification | Recombinant Monoclonal |
| Clone | K01_1P58 |
| Concentration | 1 mg/mL |
| Conjugate | Unconjugated |
| Formulation | 50mM tris glycine with 150mM NaCl, 0.05% BSA, 40% glycerol and 0.01% sodium azide; pH 7.4 |
| Gene | Trip10 |
| Gene Accession No. | Q15642, Q8CJ53 |
| Gene Alias | AI646975; Cdc42 interacting protein-4; cdc42-interacting protein 4; Cip4; hSTP; protein Felic; Salt tolerant protein; salt tolerator; STOT; STP; thyroid hormone receptor interactor 10; thyroid receptor-interacting protein 10; TR-interacting protein 10; TRIP10; TRIP-10 |
| Show More |
Product Title
By clicking Submit, you acknowledge that you may be contacted by Fisher Scientific in regards to the feedback you have provided in this form. We will not share your information for any other purposes. All contact information provided shall also be maintained in accordance with our Privacy Policy.
Spot an opportunity for improvement?